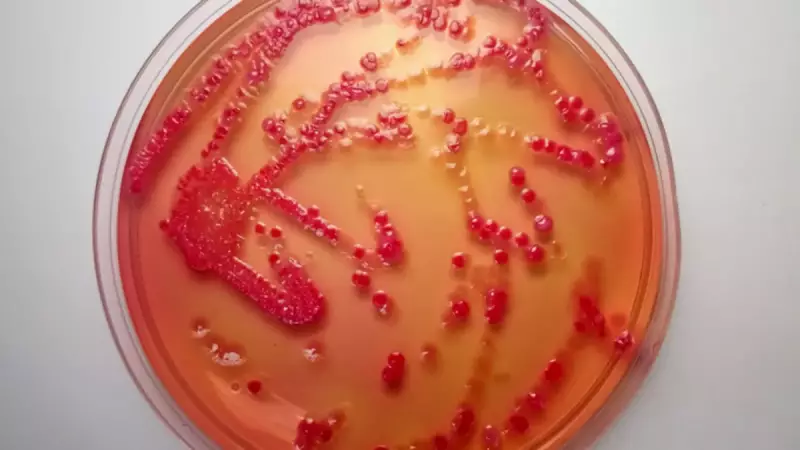
Tifo Salgını Kontrolden Çıkıyor: Antibiyotikler Etkisiz Kalıyor

Antik çağlardan beri insanlığın kâbusu olan tifo hastalığı, modern dünyada yeniden büyük bir tehdit olarak karşımıza çıkıyor. Salmonella enterica serovar Typhi bakterisinin neden olduğu bu ölümcül hastalık, artık mevcut antibiyotiklere karşı hızla direnç geliştiriyor.
Küresel Yayılım ve Araştırma Sonuçları
2022 yılında yapılan uluslararası bir araştırma, alarm verici sonuçlar ortaya koydu. Nepal, Bangladeş, Pakistan ve Hindistan'dan alınan 3.489 örneğin incelenmesiyle, yaygın ilaçlara dirençli XDR Typhi türlerinin hızla yayıldığı tespit edildi.
Ampisilin, kloramfenikol ve trimetoprim/sülfametoksazole gibi temel antibiyotiklere karşı direnç gösteren bu süper bakteri, artık yeni nesil antibiyotikler olan florokinolonlar ve sefalosporinlere karşı da direnç geliştiriyor.
Dirençli Türlerin Küresel Yayılımı
Bu tehlikeli gelişme sadece Güney Asya ile sınırlı kalmıyor. Araştırmalar, dirençli tifo türlerinin Afrika, Güneydoğu Asya, Kanada, ABD ve İngiltere'ye kadar uluslararası alanda yayıldığını gösteriyor.
Uzmanların vurguladığı en kritik nokta ise tifo vakalarının tedavisinde geriye sadece azitromisin adlı ilacın kalmış olması. Ancak bu ilaca karşı da direnç gelişmeye başladığı belirtiliyor.
Kritik Uyarılar ve Acil Çözüm Önerileri
Eğer bu direnç yaygınlaşırsa, tifo tedavisinde ağızdan alınan hiçbir ilacın etkili olamayacağı uyarısı yapılıyor. 2024 yılı verilerine göre 13 milyondan fazla tifo vakası bildirildi ve tedavi edilmediği takdirde ölüm oranının yüzde 20'ye kadar çıkabildiği kaydedildi.
Bilim insanları, bu küresel tehditle mücadele için acil önlemler alınması gerektiğini vurguluyor. Aşı kullanımının yaygınlaştırılması ve yeni antibiyotik araştırmalarına yatırım yapılması en kritik çözüm önerileri arasında yer alıyor.
Antibiyotik direnci konusunda küresel işbirliğinin şart olduğunu belirten uzmanlar, aksi takdirde binlerce yıldır insanlığı tehdit eden bu hastalığın modern çağda kontrol edilemez hale gelebileceği konusunda uyarıyor.






